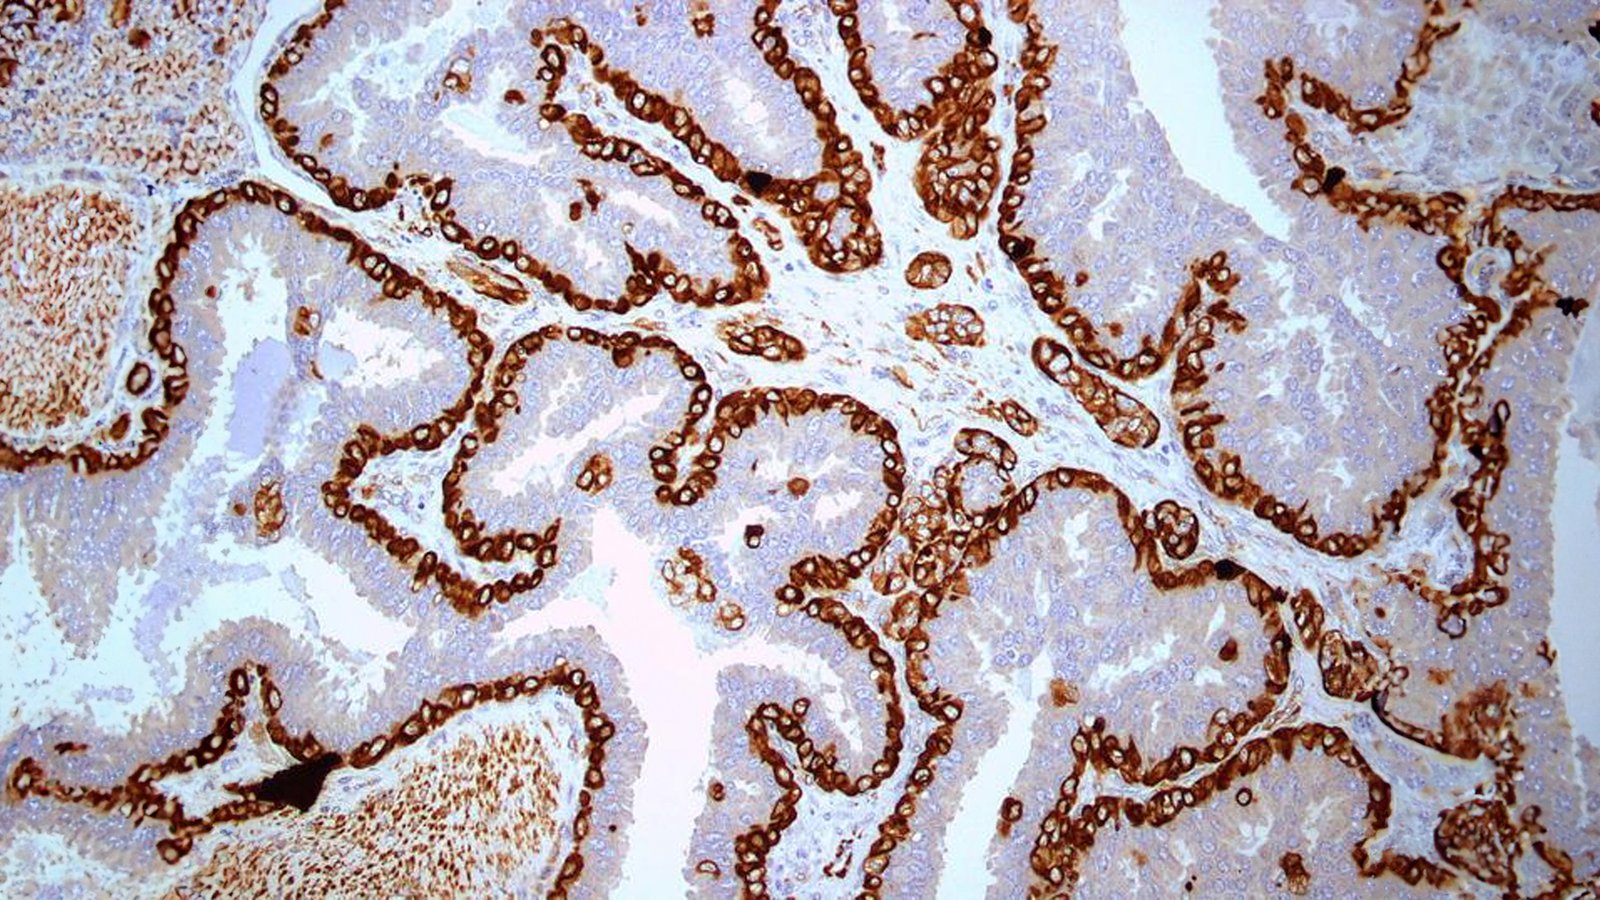
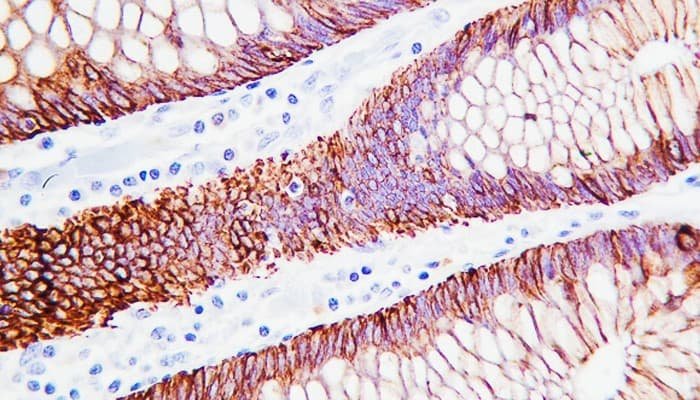

CELHIX
Servicios Médicos Confiables e Innovadores
Comprometidos en brindar servicios médicos de alta calidad a través de una estrecha colaboración con laboratorios y proveedores líderes, asegurando resultados confiables y un servicio excepcional al cliente.

CELHIX
Mejorando la Calidad, Confianza e Innovación
Implementamos estrictos controles de calidad y cumplimos con las normativas sanitarias más exigentes, lo que garantiza productos seguros, eficaces y confiables para nuestros clientes y pacientes.